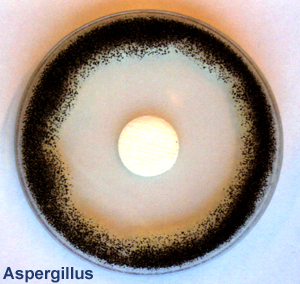

Publicado el 07-06-2017 por Fakolith Chemical Systems
¿Cómo infecta el moho (hongos) nuestras casas, y cómo lo podemos solucionar?
Las infecciones de hongos y levaduras (moho) en el interior de edificios provoca silenciosamente a sus inquilinos, infecciones cutáneas, alergias, dolores de cabeza, náuseas, asma, irritación de los ojos, piel, dolores musculares, cansancio, alergias de todo tipo e incluso problemas muy serios de salud en personas inmunodeprimidas, como la aspergilosis.
Los métodos tradicionales para eliminar el moho de paredes y techos de nuestras viviendas y edificios no funciona, es decir la lejía y la pintura plástica convencional antimoho no funcionan. Estos métodos tradicionales blanquean y maquillan el problema un tiempo, para después facilitar su rápida expansión y crecimiento con más fuerza.
A continuación un informe detallado, donde Fakolith como especialista de referencia en soluciones contra infecciones de mohos y bacterias en hospitales, industria, edificios y viviendas, expondrá una sencilla solución adaptada para su uso en hogares y viviendas, en un completo KIT Antimoho, para con 3 pasos eliminar los problemas de mohos por muchos años:
- Limpieza adecuada de daños de humedad causados por hongos y esporas.
- Consolidación y bloqueo de la infección en el interior de la superficie.
- Pintado final con pintura de alta resistencia a la humedad, moho, bacterias y microorganismos.
1. Introducción a los hongos
 Muchos materiales pueden ser cultivo de una colonia de hongos, ya que existe una gran cantidad de especies, y consecuentemente, un enorme abanico de características y capacidades de desarrollo sobre diferentes substratos y condiciones. Se clasifican en 2 tipos:
Muchos materiales pueden ser cultivo de una colonia de hongos, ya que existe una gran cantidad de especies, y consecuentemente, un enorme abanico de características y capacidades de desarrollo sobre diferentes substratos y condiciones. Se clasifican en 2 tipos:
- Las levaduras: son hongos unicelulares que por lo general se reproducen a través de yemas que van creciendo hasta que se desprenden y forman un nuevo individuo.
- El moho: son hongos pluricelulares y están formados por elementos tubulares lamados hifas” que van creciendo, ramificando y entrelazando. Una parte, se introduce en el interior de la superficie donde se alojan, que puede ser cualquier superfie: paredes, techos, plásticos, madera, muebles, textiles, etc. Otra parte crece en la superficie exterior presentando un aspecto de vello mate o algodonoso. Se reproducen por esporas que son las que le dan el color característico al moho, y le sirve para reproducirse y ser transportado ya sea por el aire, agua o a través de los insectos. Las esporas son muy resistentes a cualquier tratamiento para destruirlas.
Los lugares idóneos de nuestras casas para reproducirse son aquellos en los que exista humedad, materia orgánica y poca ventilación; baños, cocinas, dormitorios, esquinas, detrás de muebles, en marcos de ventanas, y especialmente zonas están orientadas al norte (Europa).
Sabido es que muchas de las enfermedades de las plantas y cultivos están causadas por hongos, por lo que las cosechas deben ser tratadas con fungicidas adecuados. Su capacidad de reproducción por esporas, es una de las características para que los encontremos en infinidad de lugares. En muchas ocasiones la exposición del moho a corrientes ligeras de aire ya puede provocar la propagación de sus diminutas esporas, o simplemente la adhesión de estas a los insectos también resulta rápido medio.
Los mohos se encuentran por todas partes (suelo, agua, plantas...) y son transportados por el aire, materiales, envases, animales, seres humanos, etc. Del mismo modo que ciertos hongos encuentran en las plantas un caldo de cultivo adecuado, hay otros que encuentran un buen medio de vida en las edificaciones, y al igual que en el campo afectan a las plantas y árboles, en nuestros edificios, estos afectan a la salud de personas y animales, tanto directa como indirectamente.
Si bien muchos hongos no son perniciosos para la salud, y los encontramos incluso en muchos alimentos, como puede ser en gran variedad de quesos, e incluso cabe destacar el descubrimiento de la Penicilina, por Alexander Fleming, a través del beneficioso hongo común Penicillium chrysogenum, nos llaman más la atención los aspectos negativos que muchas especies de hongos pueden tener, y por eso nos centraremos en su aspecto tóxico.
2. ¿Qué riesgos albergan los hongos?
 Según se desprende de los estudios que las mutuas de accidentes han realizado en la EU, que se ha supuesto durante mucho tiempo, que las consecuencias de un contacto prolongado con los hongos causaban como mucho o bien una infección cutánea y/o vías respiratorias, o una alergia. El hecho de que los productos del metabolismo de los hongos, las micotoxinas, altamente tóxicas, también supongan un riesgo para la salud no fue considerado por la medicina hasta más tarde.
Según se desprende de los estudios que las mutuas de accidentes han realizado en la EU, que se ha supuesto durante mucho tiempo, que las consecuencias de un contacto prolongado con los hongos causaban como mucho o bien una infección cutánea y/o vías respiratorias, o una alergia. El hecho de que los productos del metabolismo de los hongos, las micotoxinas, altamente tóxicas, también supongan un riesgo para la salud no fue considerado por la medicina hasta más tarde.
Si bien, y aunque parezca mentira, infecciones de hongos han sido capaces desde averiar el motor de un Jet, provocar la pudrición de una producción entera de barcas neumáticas, contaminar producciones enteras de alimentos y bebidas, e incluso hasta provocar incendios en instalaciones eléctricas, también son capaces de afectarnos negativamente en lo que a nuestra salud respecta, tanto en nuestros hogares como en lugares públicos, centros de trabajo e industria.
Hasta el momento, se tenía constancia que las infecciones de hongos en el interior de edificios provocaba a sus inquilinos, infecciones cutáneas, alergias, dolores de cabeza, náuseas y trastornos respiratorios, pero ahora se sabe que los hongos pueden provocar serios trastornos para la salud. No todos los hongos presentan riesgo para el ser humano, pero la existencia de alguno, ya es evidencia para que este vaya acompañado de otros que sí lo son.
Hoy en día se sabe que algunos de los síntomas básicos que provocan son:
- Asma y problemas respiratorios
- Irritación de los ojos
- Dolores musculares
- Cansancio
- Fallos del sistema nervioso
- Alergias
Este riesgo se hace especialmente grave en Hospitales donde las infecciones nosocomiales, infecciones relacionadas con la atención hospitalaria, son especialmente graves. Más info en el siguiente informe 'Cerrando el paso a las infecciones nosocomiales'.
3. Pongamos un ejemplo habitual, el hongo Aspergillus.
Si bien existen más de 900 especies de Aspergillus, sólo unas doce se relacionan con enfermedades humanas. Entre las más tóxicas, que desarrollan graves enfermedades, son las siguientes; Aspergillus fumigatus, Aspergillus flavus, Aspergillus niger, entre otras. El Aspergillus es un hongo oportunista, es decir que afecta a personas con mecanismos de defensa comprometidos. Tiene una serie de características que lo hacen uno de los primeros candidatos para desarrollarse en el ser humano; el pequeño tamaño de sus conidias permite que su transmisión por el aire y por tanto su inhalación sea muy fácil, su capacidad de desarrollarse óptimamente a 37ºC, su capacidad de adherencia a superficies epiteliales y endoteliales, su tendencia a invadir los vasos sanguíneos, y su capacidad de producción de toxinas para las células de los mamíferos, etc…
Si bien existen más de 900 especies de Aspergillus, sólo unas doce se relacionan con enfermedades humanas. Entre las más tóxicas, que desarrollan graves enfermedades, son las siguientes; Aspergillus fumigatus, Aspergillus flavus, Aspergillus niger, entre otras. El Aspergillus es un hongo oportunista, es decir que afecta a personas con mecanismos de defensa comprometidos. Tiene una serie de características que lo hacen uno de los primeros candidatos para desarrollarse en el ser humano; el pequeño tamaño de sus conidias permite que su transmisión por el aire y por tanto su inhalación sea muy fácil, su capacidad de desarrollarse óptimamente a 37ºC, su capacidad de adherencia a superficies epiteliales y endoteliales, su tendencia a invadir los vasos sanguíneos, y su capacidad de producción de toxinas para las células de los mamíferos, etc…
Este hongo, al igual que otros no citados, puede causar diversas micosis, enfermedades alérgicas que afectan a la piel, vista, oídos, aparato respiratorio, etc… y provocando desde una infección local, hasta cuadros clínicos muy graves; Onicomicosis, Otomicosis, Sinusitis, Aspergilosis broncopulmonar alérgica, Aspergilomas, Aspergilosis pulmonar invasiva o necrosante crónica, y otras manifestaciones sistemáticas que afectan a diversos órganos, como el cerebro, bazo, estómago, hígado y riñones. Más detalle en el informe completo 'Mohos y bacterias en edificios'.
4. Hongos en los edificios en general
Podemos afirmar casi a ciencia cierta, que todas las edificaciones albergan moho. Muchos productos manufacturados utilizados en nuestra vida cotidiana, son susceptibles de ataque por hongos. Así pues, paredes pintadas, zonas de lugares húmedos, pueden ser cubiertas tanto por su exterior como por su interior por ciertas clases de hongos. Maderas y productos derivados de la celulosa y textiles, pinturas orgánicas, son también un especial medio de rápido desarrollo.
Algo evidente es que por regla general los hongos necesitan de un umbral mínimo de humedad para su desarrollo AW. De este modo, la existencia de una infección de hongos puede tener su origen en muchos lugares: en duchas y baños, tras escapes agua y en obras de remodelación, tejados con necesidad de reparación, en paredes cara norte, donde haya condensación por ventilación inadecuada, en procesos productivos industriales, etc, tanto en la industria, en lugares públicos, como en el hogar.
Hoy en día disponemos de ventanas herméticas con acristalamiento aislantes, sistemas de aislamiento térmico por el interior y exterior de los edificios, los suelos son a menudo de materiales sintéticos y las paredes están recubiertas con pinturas plásticas no transpirables. La insuficiencia en la ventilación, principalmente, crea puntos de condensación por diferencial térmico, que incentivan el crecimiento de los hongos.
5. La ventilación natural controlada, la mejor prevención básica en viviendas.
En la era de la tecnología y del ahorro energético, tenemos que acostumbrarnos a que un edificio, igual que cualquier otra instalación técnica, exige un mantenimiento. La estanqueidad, aislamiento y ahorro energético de los edificios es ya una característica de calidad significativa. Si se quieren reducir el consumo de energía para calefacción y la consiguiente emisión de CO2, el camino para alcanzar este objetivo pasa por una aislamiento máximo de los edificios, pero con una ventilación suficiente y controlada, o la consecuencia será, edificios insanos.
La posibilidad más sencilla, y al alcance de cualquiera, para ventilar un edificio, es la renovación del aire a través de las ventanas. Para las viviendas, tanto las de obra nueva como las antiguas, se puede optar por la ventilación frecuente, o la ventilación breve pero intensa. Más detalle en el informe completo 'Mohos y bacterias en edificios'.
6. ¿Cómo podemos prevenir y solucionar infecciones de moho? Kit Antimoho BioFilmStop
 La medicina se encarga del tratamiento de estas infecciones en el cuerpo humano (micosis). Pero consideramos que la prevención en general es un factor muy a tener en cuenta, tanto en zonas privadas, como en la industria, el lugar de trabajo, así como indispensablemente en zonas de alto riesgo, como indudablemente nuestras viviendas.
La medicina se encarga del tratamiento de estas infecciones en el cuerpo humano (micosis). Pero consideramos que la prevención en general es un factor muy a tener en cuenta, tanto en zonas privadas, como en la industria, el lugar de trabajo, así como indispensablemente en zonas de alto riesgo, como indudablemente nuestras viviendas.
Nuestros sistemas de protección para superficies de paredes y techos afectadas por humedad y moho, son ampliamente conocidos en los sectores sanitario y alimentario, y la solución se traslada al ámbito particular gracias al práctico y sencillo Kit Antimoho de Fakolith para 10 m², que incluye:
- 1 l. del limpiador de daños de mohos y humedad: FK-12
- 1 l. de la imprimación consolidante de alta resistencia al mohos: Disperlith Primer
- 2,5 l. de la pintura especial con tecnología BioFilmStop: DISPERLITH Industry
Y además: Informe mohos en edificios, Instrucciones de seguridad, Guía de aplicación, Guantes y mascarilla, Gafas de protección, Esponja para limpieza.
LINKS
INFORME COMPLETO MOHOS Y BACTERIAS EN EDIFICIOS: https://www.fakolith.es/docs/mohos-bacterias-y-biofilm-en-edificios-industria-alimentaria-sector-sanitario-hogar-fakolith.pdf
KIT ANTI-MOHO: https://www.fakolith.es/kit-antimoho-limpiador-imprimacion-pintura-biofilmstop-kit-antimoho-_producto_298.html
VIDEO KIT ANTI-MOHO: https://www.youtube.com/watch?v=EujyYNakvv0